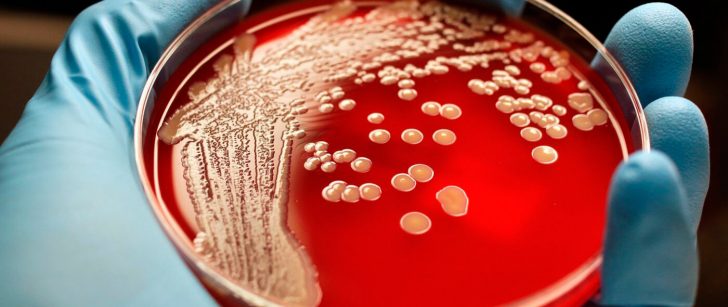

Стадії і ступеня стафілокока в носі
Стафілокок в носі (симптоми у дорослих пов’язані з утрудненням носового дихання) має 4 умовних стадії, які відрізняються наявністю тієї чи іншої патологічної активності.
| I стадія | Інфекція локалізована в носовій порожнині. Видима симптоматика захворювання відсутня. При нормальному функціонуванні захисних сил організму лікування медикаментами не потрібно. |
| II стадія | Прояви захворювання мінімальні. Призначаються діагностика для дослідження наявності інших видів бактерій. При необхідності застосовують антибактеріальну терапію. |
| ІІІ стадія | Симптоматика захворювання, викликана бактерією, активно проявляється. Пацієнту призначають медикаментозне лікування, спрямоване на зміцнення імунітету. |
| IV стадія | Симптоми яскраво виражені, спостерігається загальна інтоксикація організму з-за підвищеної температури. Лікування включає застосування імуномодуляторів і антибактеріальних препаратів. |
Розрізняють 4 ступеня стафілокока, що визначають інтенсивність його росту:
- 1 ступінь – повільний ріст колоній.
- 2 ступінь – кількість колоній не перевищує 10.
- 3 ступінь – кількість колоній варіюється від 10 до 100
- 4 ступінь – наявність більше 100 колоній.
При розшифровці досліджуваного біоматеріалу показники з 1 і 2 ступенем свідчать про наявність стафілокока, з 3 – про початок перебігу захворювання, з 4 – про розвиток вираженого запалення.
ПРИЧИНИ І СИМПТОМИ
Необхідно розрізняти носійство стафілокока і стафілококову інфекцію. Якщо аналіз показав, що в носі є стафілокок, але немає реальних симптомів хвороби, то для занепокоєння немає приводу.
В таких ситуаціях не потрібно ковтати антибіотики або намагатися вилікувати себе іншими медикаментозними засобами. Оптимальним кроком буде прийняття заходів по зміцненню імунітету. Сильному організму стафілокок не небезпечний.
Навпаки, при розвитку інфекції без лікування не обійтися. Стафілококова інфекція – стан, при якому бактерії активізувалися і стали причиною захворювання носоглотки.
Характерні симптоми стафілококової інфекції:
- збільшення температури тіла;
- нежить, в тому числі гнійний;
- загальне нездужання;
- болі в зіві;
- втрата голосу;
- втрата нюху;
- постійна закладеність носових ходів;
- біль у носових пазухах;
- поява в’язкого слизу в горлі;
- слизова носоглотки розпухає і червоніє;
- у носі і під ніздрями з’являються гнійнички;
- свербіж в ніздрях.
Без лікування інфекція переходить у хронічні лор-захворювання, зазвичай в риніт. Якщо патологічний процес не зупинити, риніт переходить у ангіна, гайморит або отит.

Поразка слизової цією недугою можна розпізнати відразу, так як виникає ряд проявів, властивих саме для цього мікроорганізму:
- шкіра у носових пазухах та навколо них набуває червоний колір;

Стафілокок провокує запальний процес, який поширюється на шкіру навколо носових пазух - з’являється нежить;
- слизові виділення прозорі, потім з’являються вкраплення гнійних мас;
- пазухи забиті, створюється складність у диханні;
- відбуваються зміни у звучанні голосу — людина сипить і гугнявить;
- доводиться дихати ротом, що негативно позначається на стані гортані, збільшується ризик запалення горла та бронхів;
- людина втрачає нюх;
- підвищується температура, переважно до 38 градусів (якщо приєднується запальний процес, то стовпчик термометра може показати 39 градусів і вище);
- самопочуття сильно погіршується, з’являються загальна слабкість, порушення сну, викликані неможливістю нормального дихання.
При подальшому розвитку золотистого стафілокока міцно забиваються носові пазухи, що сприяє розвитку гаймориту.
Інші симптоми, характерні для стафілококової інфекції:
- почервоніння і набряк повік;
- біль м’язів на обличчі (на вилицях і під очима);
- зубний біль.
Особливу небезпеку інфекція золотистого стафілокока представляє для дітей. Крім основної симптоматики, у них можуть додаватися:
- утворення абсцесів;
- сепсис;
- поразка обох легенях, мозку, кісткової системи, печінки, серцевого м’яза;
- освіта висипання на шкірних покривах;

У дитини гнійні висипання можуть поширюватися по всій шкірі обличчя - свербіж у носі;
- збільшення аденоїдів.
Звичайно, ці стани виникають не відразу, а при відсутності своєчасного лікування або його неправильною схемою.
Гнійні запалення слизової носа – ознаки захворювання стафілококом. Під час розвитку стафілокока в носі симптоми можуть приймати характер інших захворювань.
У патогенном стані стафілокок є причиною наступних симптомів:
- підвищена температура тіла;
- закладеність носа;
- білі, зелені виділення з неприємним запахом з носа;
- придаткові пазухи носа заповнені гноєм;
- болі в лобовій частині голови;
- відкритий рот;
- важке дихання;
- хропіння під час сну;
- висип на тілі;
- слабкість, швидка стомлюваність.

Якщо вчасно не вилікувати захворювання, інфекція часто поширюється по горла, вух, викликаючи запалення в цих областях відповідно.
Золотистий стафілокок в носі і горлі
Найпоширенішим місцем ураження стафілококової інфекцією є слизова горла і носа. При цьому не всі люди можуть запідозрити збудника на початковому етапі.
Виявити наявність стафілокока допомагають наступні симптоми:
- Постійний нежить.
- Тривалий час тримається підвищена температура тіла.
- Виникнення інтоксикації.
- Проблеми з травною системою.
- Поява різних порушень шкірних покривів у вигляді виразок, прищиків або гнійників.
- Закладеність носа.
Ознаками стафілокока при ураженні носа, горла і носоглотки виступає помітна набряклість і почервоніння мигдаликів, збільшення розмірів лімфатичних вузлів, а також біль і наявність гною.
Якщо вище перераховані симптоми є частиною життя, можна з упевненістю припустити про розвиток стафілокока в носі і горлі. У такому випадку необхідно звернутися до медичного фахівця і пройти обстеження.
1. Риніт – запальний процес, що характеризується:
- виділення слизу;

- ускладненням процесу дихання;
- зниження тембру голосу;
- порушення чутливості смакових рецепторів і почуття нюху.
2. Синусит – запалення придаткових пазухах носа, яке проявляється:
- нежиттю з виділенням жовто-зеленої слизу;
- слабкістю, швидкою стомлюваністю;
- підвищенням температури тіла до 37,5-39С;
- відсутністю апетиту;
- біль у ділянці пазух.
3. Фарингіт – запалення слизової оболонки глотки, симптомами якого є:
- утворення в’язкого слизу в області стінки горла;
- сухий кашель;
- осиплість голосу;
- підвищена температура тіла.
4. Гайморит з вираженими симптомами:
- головний біль;
- набряк слизової;
- закладеність носа;
- виділення коричневого секрету і гнійного ексудату з носа.

Стафілокок викликає гайморит (симптоми на картині) носа, тонзиліт в горлі.
До загальних симптомів відносять ознаки інтоксикації організму:
- підвищення температури тіла;
- слабкість;
- нудота;
- запаморочення;
- наявність гнійничкових висипань на слизовій оболонці носа.
У більшості випадків людина навіть не підозрює про те, що він, виявляється, носій стафілококової інфекції. Пацієнти стверджують, що виявити цей шкідливий мікроорганізм вдалося лише після того, як вони пройшли спеціальні обстеження.
- безперервному нежиті;
- підвищеної без всякої на те причини температурі тіла;
- симптомів, характерних для інтоксикації.
Зовсім не обов’язково, що будуть проявлятися всі перераховані симптоми. Досить навіть одного нежиті, якщо він перейшов у хронічну форму. Часто хвороба взагалі ніяк себе не видає. Однак це не говорить про те, що людина повністю здоровий.
Традиційно розрізняють 3 ступеня стафілокока. У кожної з них свій рівень активності і розмноження. Відповідно, і лікування буде відрізнятися. Отже, стафілокок в носі буває:
- безумовно патогенних (знищує клітини крові);
- умовно патогенних (провокує уповільнений запальний процес);
- сапрофитом (майже не позначається на здоров’ї).
На носі золотистий стафілокок утворюється в основному з причини різких порушень у механізмі роботи захисної системи організму.
- Сильні переохолодження.
- Важкий період акліматизації і недостатня адаптація до нових умов.
- Лікування одночасно поточних інфекційних захворювань протимікробними препаратами, які мають форму крапель.
- Неправильний підбір антибіотичних засобів при лікуванні хвороб.
Люди, які часто використовують засоби, які сприяють звуженню судин в носі, входять в основну групу ризику по золотистому стафілококу, а при постійних нервових перенапруженнях, порушення психоемоційного стану і стресах ймовірність зараження – максимальна.

Також хвороба може почати активний розвиток після попадання на слизову оболонку носа великої кількості патогенних бактерій (при контакті з хворим), а також при використанні спільних з інфікованою людиною речей та засобів гігієни.
- Повітряно-крапельний.
- Контактно-побутовий.
- Аліментарний.
- Артіфіціальним.
- Повітряно-пиловий.
Симптомами золотистого стафілокока в носі найчастіше є постійний нежить (риніт) і ускладнення процесу дихання.
Симптоми:
- Виділення секрету у вигляді прозорого слизу на початку захворювання, яка в ході розвитку хвороби стає густішим з-за домішок гною.
- Різка зміна голосу – він стає гугнявим і сиплим.
- Різкий стрибок температури тіла до 38, а іноді і до 39 градусів.
- Поява гнійників і почервоніння шкірного покриву в області навколо носа.
- Втрата можливості відчувати запахи.
Для хвороби характерно постійне дихання ротом, що часто призводить до безсоння і, як наслідок цього стану, до високої дратівливості.
- Гайморит: закладений ніс, сильний нежить, озноб, сильні зубні і головні болі, набряки повік.
- Фронтит: сильна слабкість і підвищена втома, часті запаморочення, нестерпні головні болі.
- Атрофія слизових оболонок носа: відчуття свербежу і сильної сухості.
ЗАХВОРЮВАННЯ, СПРОВОКОВАНІ ЗОЛОТИСТИМ СТАФІЛОКОКОМ
Після прояву симптомів золотистого стафілокока та його поширення по організму можуть виникнути наступні захворювання.
З найбільш частих ускладнень зустрічаються хвороби носової порожнини, такі як риніт, фарингіт, гайморит і синусит.
- Ларингіт.
- Бронхіт.
- Остеомієліт.
- Пневмонія.
- Піодермія.
- Гостре харчове отруєння.
Існує кілька способів отримання бактерій людиною:
- повітряно-крапельний шлях;
- період внутрішньоутробного розвитку, розродження, годування груддю;
- повітряно-пиловий шлях;
- контактно-побутовий шлях.
Повітряно-крапельний шлях – повітря, заражена стафілококом, природним шляхом потрапляє в носову порожнину людини. Носії інфекції виділяють бактерію при чханні.
Період внутрішньоутробного розвитку, розродження, годування груддю: у більшості випадків новонароджені діти заражаються від матері гематогенним шляхом, при приляганні плаценти, порушення пологової діяльності.
Повітряно-пиловий шлях – при чханні зараженим людиною, бактерії осідають на пилу. Зараження відбувається при вдиханні.
Контактно-побутовий шлях – інфекція потрапляє в організм людини при використанні предметів особистої гігієни, посуду хворої людини.
Зародившись у носових пазухах вогнище запалення не стоїть на місці, а повільно переходить на органи горла, вражаючи гортань, мигдалики, трахеї. Після цього захворювання перетікає на серце, печінку, шлунково-кишковий тракт.
Клінічна картина: пацієнт, хворий ринітом, не приймає заходи по одужанню, призначені лікарем. Через декілька днів хворий скаржиться на болі в горлі, а ще через кілька днів починає боліти шлунок, печінка.
Діти, літні люди більше за інших піддаються небезпеки. Крім ураження органів горла, можуть виникати абсцеси, ураження кісток, легенів, серця, мозку. У запущених випадках стафілокок в носі – причина септичного зараження крові.
Після огляду лікаря для постановки точного діагнозу, пацієнт здає кров, мазок на бак. посів слизової.
Види діагностики:
- мікробіологічна;
- серологическая;
- інструментальна.

Мазок, взятий з носа, порожнини рота вивчають на присутність бактерій. Кожному виду інфекції підібраний матеріал, що забарвлює звичайний стафілокок в жовтий колір. Золотистий вид бактерії змінює на каламутні пластівці жовті бактерії.
Аналіз не дає точних показників присутності золотистого стафілокока в організмі. Для стафілокока інших видів його результати показують присутність мікроба 102. Для золотистого стафілокока є інші показники, ступінь дорівнює 0.
При виявленні бактерії негайно призначають лікування. Інтенсивна терапія триває протягом семи днів, після чого медики призначають препарати для підтримуючої терапії, щоб уникнути рецидиву, зміцнення ослабленого імунітету.
Рентгенографія визначає ступінь ускладнення інфекції.
Майбутнім матерям необхідно підтримувати імунітет, берегтися від будь-яких інфекцій. При захворюванні висока ймовірність ураження плодових оболонок, плід іноді хворіє.
Якщо при зборі аналізів виявлено золотистий стафілокок, призначають лікування стафілокока в носі і в горлі.
Вагітній необхідно постійно полоскати горло, для порожнини носа використовувати мазі. Вживати вітамінні комплекси для вагітних.

Через кілька тижнів лікування призначають повторні аналізи.
Зазвичай інфекція виникає саме в носоглотці, так як вона позитивна для поселення автогенных бактерій. Якщо золотистий стафілокок в носі почав швидко розвиватися, то це обов’язково буде супроводжуватися такими симптомами:
- зміна голосу;
- розлади нюху;
- регулярна закладеність носа;
- нежить з гнійною мокротою;
- поява в’язкого слизу;
- гіперемія слизової носоглотки;
- поява гнойниковых ран в носі і під ним;
- регулярний свербіж в носових проходах.
Це лише місцеві симптоми, які має золотистий стафілокок, симптоми у дорослих можуть бути загальними. До них відносяться:
- підвищення температури тіла;
- болі в голові;
- поява висипань на тілі;
- інтоксикація;
- болі в животі;
- діарея;
- збільшення газоутворення в кишечнику.
Захворювання не завжди виліковується повністю і при неправильно вибраному методі лікування інфекція переходить у регулярне носійство з розвитком хронічного риніту.
Небезпека цієї інфекції полягає в тому, що вона дуже швидко поширюється на сусідні органи. У віддалені органи вона потрапляє лімфогенним шляхом. Найчастіше перші прояви стафілокока в носі пов’язані з прогресуванням гострої форми риніту.
- ангіни;
- гаймориту;
- гострого аденоїдиту;
- отиту.
Величезну небезпеку золотистий стафілокок в носі несе для тих людей, які страждають слабенькою опірністю організму. В цьому випадку інфекція може потрапляти в легені і викликати там ускладнення.
Можливе ураження головного мозку, серця, нирок. У разі ускладнень хворим необхідно перебувати в стаціонарі під суворим наглядом лікаря. Бактерії можуть призводити до коми, токсичного шоку і навіть летального результату.
Золотистий стафілокок може також стати причиною фронита. У цьому випадку у хворого починають з’являтися дуже сильні головні болі в області чола. Починає виникати загальна слабкість, регулярна стомлюваність, запаморочення.
Досить часто інфекція призводить до гаймориту. У цьому випадку у пацієнта з’являється озноб, закладеність носа, чхання. При прогресуванні повіки почнуть набрякати, з’являться больові відчуття на обличчі.
Золотистий стафілокок є найагресивнішим представником цього виду мікроорганізмів. Причиною дуже багатьох небезпечних захворювань є саме золотистий стафілокок. Як передається інфекція? Джерелом можуть стати медичні інструменти, які були погано оброблені, внутрішньовенне харчування.
Розвиватися інфекція може розпочати після ряду перенесених хвороб, які послабили імунітет. До них належать грип, ГРВІ, травми, дисбактеріоз. Можливо прогресування після хірургічного втручання чи різних медичних процедур.
Досить часто інфекція розмножується на продуктах харчування. Разом з їжею вона проникає в організм людини. Зазвичай з’являється на солодкої продукції, м’ясі, яйцях, молочної продукції. Ентеротоксин інфекції несе величезну небезпеку для організму, так як здатний викликати важкі отруєння. Після цього з’являються сильні болі в животі, блювота, діарея.
Інфекція може передаватися через подряпини або рани, а також від матері до дитини. При годуванні груддю інфекція потрапляє до дитини через грудне молоко. Якщо бактерії потрапляють до матері через тріщини на сосках, то це стає причиною гнійного маститу. Досить велика ймовірність зараження при чханні, кашлі і навіть при диханні.

При появі будь-яких симптомів обов’язково потрібно звернутися до отоларинголога. Фахівець проведе фізикальне обстеження, подивиться історію хвороби хворого. Для визначення наявності інфекції необхідний бактеріальний посів на живильне середовище.
За тиждень до аналізу не приймати ніяких антибактеріальні препарати. В цьому випадку можна буде отримати максимально точний аналіз. Аналіз виконується протягом 7 днів.
Причиною гнійників стає золотистий стафілокок в носі. Лікування у дорослих проводиться за допомогою антибіотиків. Метод лікування хворого підбирається індивідуально лікарем. Зазвичай антибактеріальні препарати призначаються у вигляді таблеток або ін’єкцій.
Складність лікування полягає в тому, що бактерія не піддається лікуванню препаратами пеніцилінового ряду. Під час обстеження фахівці визначають чутливість бактерій до антибіотиків. Щоб лікування дало максимальний результат потрібно проводити його комплексно. Зазвичай для лікування інфекції прописують такі антибактеріальні препарати:
- Ванкоміцин, Оксацилін, Цефтріаксон, Диклоксацилін;
- з макролідів можуть бути призначені: Еритроміцин, Азитроміцин;
- добре себе зарекомендували такі цефалоспорини: Цефалексин, Цефалотин.
У разі важкої форми патологічного процесу хворим призначається специфічне лікування. У цьому випадку показано імуноглобулін або анатоксин. Препарати допоможуть усунути інтоксикацію. В окремих випадках можуть вводитися антистафилококковые бактеріофаги, які застосовуються у разі протипоказань до антибіотиків.
Як лікувати золотистий стафілокок? При виявленні стафілокока в носі ефективно можуть використовуватися наступні системні препарати:
- Иммуномодуляторного типу, які призначені для стимуляції загальної резистентності організму хворого. Зазвичай призначаються Тактивін, Полудан, Иммунорикс.
- Вітамінно-мінеральні комплекси. Ефективними є Алфавіт, Вітрум, Супрадин.
- Антигістамінні препарати при сильному набряку слизової носа. Високою ефективністю володіють Зіртек, Діазолін, Тавегіл.
Лікувати інфекцію можна застосовуючи місцеві препарати. Серед них виділяються:
- Використання місцевих імуномодуляторів — Иммудон, ІРС-19.
- Промивання носа за допомогою антисептичних розчинів. До них відносяться Хлоргексидин, Мірамістин.
- Для носа також показано використання таких мазей: тетрациклінова, эритромициновая. Перша використовується в тому випадку, якщо з’явилися гнійники на слизовій носа.
- Використання крапель в ніс. Ефективні Изофра, Полидекса, Протаргол. При достатній закладеності носа призначають судинозвужувальні препарати.
- Якщо утворюються великі гнійники, то показано їх розтин з наступною обробкою.
- Зрошення носа Хлорофіліптом. Можливо закопування масляного розчину.
Якщо хвороба протікає не так просто, то додатково показані промивання горла перекисом водню, Фурациліном або Мірамістином.
Причини чому з’являється патогенний стафілокок епідермальний
Стафілокок в носі (симптоми у дорослих довгий час можуть носити прихований характер) активізується при послабленні захисних функцій організму під впливом провокуючих факторів.
До них відносять:
- контакт з носієм бактерії;
- тривалий прийом антибіотиків;
- стрес;
- авітаміноз;
- недотримання правил особистої гігієни;
- порушення обміну речовин;
- переохолодження;
- тривалі простудні та інфекційні захворювання.
Крім факторів розвитку бактеріальної інфекції, існують також групи людей з підвищеним ризиком зараження:
- хворі на ВІЛ;
- діабетики;
- новонароджені і недоношені;
- люди похилого віку;
- вагітні.
Бактерія стафілокок під мікроскопом
В даний час існує безліч видів стафілокока, деякі з яких завжди присутні в організмі людини, але не впливають на розвиток захворювань. Одним з таких вважається епідермальний стафілокок, він починає свою дію при впливі на організм певних факторів.
- Порушення правил особистої гігієни — всім відомо, що чистота вважається запорукою здоров’я, тому що брудне тіло і руки несуть велику кількість патогенних бактерій і мікробів, у тому числі стафілокок. Тому після відвідування туалету, перед прийомом їжі необхідно ретельно мити руки з допомогою антибактеріального мила. Також слід стежити за продуктами, овочі і фрукти бажано обдавати окропом.
- Пряме зараження відбувається шляхом звичайного рукостискання, обійми, а також при користуванні чужих косметичних приладдя або носіння не свого одягу.
- Надмірне вживання антибіотиків — згубно позначається на стані здоров’я, може призвести до проблем з травною системою, дизентерії. Безконтрольне вживання лікарських препаратів у підвищених дозах може посприяти розвитку стафілококової інфекції. Тому перед вживанням таблеток, потрібно консультуватися з лікарем.
- Зниження імунного статусу організму — головний фактор освіти хвороби горла і носа золотистим стафілококом. Воно може бути спровоковано переохолодженням, наявністю супутньої патології, нервовими перенапруженнями та отруєннями.
Додаткові відомості
Медикам відомо кілька додаткових шляхів зараження людини бактеріями:
- Продукти харчування не пройшли термічну обробку перед вживанням, мікроби, що знаходяться в кишечнику почали отруювати організм.
- Через пошкодження шкіри разом із кров’ю в організм потрапляє патогенний золотистий стафілокок.
- Переохолодження організму.
- Під час гострих респіраторних захворювань знижується загальний імунітет, тому висока ймовірність зараження.
- Стафілококову бактерію організм сприймає особливо гостро після тривалого прийому медикаментозних препаратів.
- Людям похилого віку, новонародженим легко заразитися стафілококовими інфекціями в силу свого слабкого імунітету.
- Тонзиліт, аденоїди, риніт діють позитивно на розвиток захворювання.
Способи передачі захворювання
Якщо є підозри на стафілококову інфекцію, слід провести діагностичні заходи. Вони робляться в спеціальних лабораторних установах, забір матеріалу проводиться з поверхні слизової горла, носа і зіву.
Проведення бактеріологічного посіву золотистого стафілокока
При бактеріологічному посіві необхідно дотримуватися певні рекомендації і техніку виконання, все повинно бути стерильним.
Після забору все доставляють в лабораторію і проходить посів, за результатами якого встановлюють наявність мікроба в організмі. Якщо висіявся стафілокок після посіву, це свідчить про присутність його на слизовій носа і горла.
Нормою аналізу вважається 103 КУО/мл у дорослих людей і 104 КУО в дитячому віці до року. Якщо показники виявляються вище таких значень, це говорить про поразку організму стафілококом.
Щоб вилікувати стафілокок в носі, самодіагностики буде недостатньо. Перші симптоми захворювання – привід звернутися до відповідного фахівця. Тільки лабораторні дослідження можуть з 100% вірогідністю визначити присутність в організмі людини небезпечних бактерій золотистого стафілокока в носі.
- Мікроскопія мазка, взятого зі слизової оболонки носа.
- Мясопептонний бульйон.
- Мясопептонний агар.
- Кров’яний агар.
- Соляний агар.
- БАК-посів.
- Антибіотикограма.
Всі із зазначених методів виявляють наявність бактерій золотистого стафілокока в організмі людини, а також допомагають точно визначити, до яких антибіотиків найбільш стійкі дані бактерії.
- Тейкопланін.
- Метицилін.
- Пеніцилін.
- Ванкоміцин.
Внаслідок того, що раніше золотистий стафілокок лікували тільки з допомогою пеніциліну, у бактерії виробився спеціальний фермент, що розщеплює молекули антибіотика – пеніциліназ.
В носі у дорослих стафілокок лікують в основному за допомогою антибіотичних препаратів після обов’язкової антибіотикограми.
Лікування:
- промивання носових порожнин антисептичними розчинами;
- эритромициновые і тетрациклінові мазі для носа;
- закапування носа масляними розчинами;
- імуномодулююча терапія;
- хірургічне розтин гнійників з антисептичною обробкою;
- краплі з помірною сосудосужающей функцією;
- антигістамінні засоби;
- комплекс мінералів і вітамінів;
- антистафилококковые плазми і імуноглобуліну;
- анатоксини.

Для лікування стафілокока в носі у вагітних (яким протипоказані антибіотичні засоби) використовують антистафілококовий бактеріофаг, який має широкий спектр застосування (від місцевого до внутрішньовенного).
Слід пам’ятати, що ця бактерія може бути смертельно небезпечною для людини, тому будь-які народні методи при лікуванні даного захворювання неприпустимі. Відсутність своєчасного та погодженого з лікарем лікування може викликати сепсис, кому та летальний результат!
Мета діагностики – встановити вид збудника і його штам. Для цього проводиться бактеріологічне дослідження слизового вмісту носа і гиперемированных пустул (висипань). Посів з носа проводиться на поживні середовища.
Обов’язково проводиться риноскопія порожнини носа, що дозволяє виявити стан слизової оболонки, і оцінити ступінь тяжкості захворювання. Обстеження може бути доповнено рентгенографією та комп’ютерною томографією, однак такі методи спрямовані на виявлення ускладнень.
Для визначення характеру захворювання лікар призначає ряд досліджень. Зазвичай для аналізу береться кров. Запальний процес проявляється підвищенням рівня лейкоцитів і збільшенням швидкості осідання еритроцитів (ШОЕ).
Специфічним методом діагностики є мазок із носа і зіву. З його допомогою визначають наявність патогенів. Не варто боятися проведення досліджень, так як мазок — абсолютно безболісне захід. Проводиться він так:
- Лаборант стерильною паличкою з ватним кінчиком проводить слизовій носоглотки.

Взяття мазка з носа — абсолютно безпечна і безболісна процедура - Потім у пробірку робиться посів.
- Через один-два дні проводять оцінку зростання колонії. Для кожної бактерії існують унікальні параметри.
Золотистий стафілокок являє собою круглі елементи, розташовані в чашці Петрі скупченнями - Як тільки посів дає позитивний результат, в лабораторії проводять дослідження на предмет чутливості стафілокока до антибіотиків. Цей момент дуже важливий, так як мікроорганізми стали стійкі до багатьох видів лікарських засобів. Отже, при виявленні золотистого стафілокока є можливість миттєвого визначення відповідного препарату для лікування недуги.
Діагностика стафілококової інфекції складається з лабораторних методів, що включають бактеріологічні, серологічні та загальноклінічні дослідження.
Для розпізнавання збудника та визначення його чутливості до антибіотиків здають посіви слизу, виділюваної з носа. Зібраний матеріал поміщають у стерильні пробірки і вивчають під мікроскопом. Такий вид дослідження допомагає визначити кількість та морфологічні властивості бактерій. Вартість бактеріологічного дослідження в клініках складає 500-800 руб.
Виявити бактерії різного роду допомагає їх культивація на певному середовищі.

Для вирощування колонії стафілокока, мазок з носоглотки поміщається в спеціальну живильне середовище:
- кров’яний агар;
- середовище Сабуро;
- жовто-сольовий агар;
- середовище Ендо;
- шоколадний агар.
Для дослідження матеріалу використовують також чашу Петрі – ємність у формі циліндра, на внутрішні стінки якої наноситься зібрана слиз, а потім її розсіюють. Через добу оцінюють результат, визначаючи вид та кількість бактерій.
Серологічні методи дослідження використовують у випадках, коли немає можливості здійснити збір бактеріологічних аналізів. Для визначення виду і штаму бактерій досліджують плазму крові, в якій присутні антигени, властиві стафілококу. Вартість дослідження варіюється від 500 до 1500 руб.
Додатковим способом діагностики є загальноклінічні методи – загальний аналіз крові та сечі.
Коли необхідно звернутися до лікаря
При перших проявах захворювань, викликаних дією стафілокока, потрібно звернутися в медичний заклад. На початковому етапі обстеження необхідна консультація терапевта, який в залежності від супутніх симптомів, видасть направлення на прийом до отоларинголога, інфекціоніста або імунолога.
Консультація отоларинголога необхідна у разі наявності наступного симптоматики:
- тривалий перебіг нежиті;
- підвищення температури тіла;
- зміна кольору прозорих або жовтуватих виділень з носа на жовто-коричневий або зелений;
- загальне нездужання;
- болі в ділянці носових пазух.
Крім призначень бактеріологічних аналізів, отоларинголог направить на додаткові методи дослідження – рентген пазух носа або грудної клітки. Консультація імунолога потрібна у випадку, коли стафілококова інфекція викликана зниженням активності імунної системи.
Профілактика стафілокока в носі
Основна міра профілактики – підтримання імунітету. Для цього необхідно правильно харчуватися, стежити за станом здоров’я, одягатися по погоді. Захищатися у період нестабільної епідеміологічної ситуації та мінімізувати контакт з хворими.

При виникненні ГРВІ під час обстежитися і приймати лікарські препарати. У разі бактеріального зараження не чесати скоринки в ніс і на поверхні шкіри, дотримуватися правил гігієни, використовувати окремі постільні, столові приналежності, приділяти увагу правильному харчуванню.
Стафілокок незалежно від видової приналежності небезпечний для пацієнта. Нерідко він виявляється в карбункулах, фурункулах і на слизових оболонках верхніх дихальних шляхів. На місці висипань деколи залишаються дрібні рубці, що свідчать про ураження нижніх шарів дерми.
Відео по темі:
Небезпечний виявлений в носі стафілокок?
03:01
Золотистий стафілокок. Що робити?
02:58
золотистий стафілокок в носі і в горлі
10:48
★Народні засоби лікування ЗОЛОТИСТОГО СТАФІЛОКОКА. Профілактика зараження.
03:05
Щоб не допустити зараження, необхідно дотримуватися деяких правил:
- потрібно стежити за чистотою в будинку. Як мінімум раз в 7 днів необхідно проводити вологе прибирання;
- іграшки дітей потрібно промивати в теплому мильному розчині, найбільш часто цю процедуру слід виконувати, якщо в будинку є діти до трьох років, які можуть брати предмети в рот;
- слід виключити вживання їжі, в якості якої немає впевненості;
- потрібно постійно займатися зміцненням імунітету.
Всі ці правила повинні бути щеплені і дитині з самого малого віку. Якщо у когось із близьких почалася стафілококова інфекція, то кожному члену сім’ї треба обстежитися і пройти лікування.
Більшість людей — носіїв золотистого стафілокока в носі. Патогенна фаза починається, коли в людини слабшає імунітет. Інфекція швидко прогресує. Лікування призначається лікарем. У цей процес входить прийняття антибіотиків, імуномодуляторів та інших допоміжних препаратів.
Не допустити розвиток бактеріальної інфекції допоможе дотримання профілактичних заходів:
- пеніциліни (Амоксиклав, Амоксицилін)

- макроліди (Еритроміцин)
- цефалоспорини (Цефотаксим)
- фторхінолони (Ципрофлоксацин)
| Амоксиклав | Володіє широким спектром антибактеріальної дії. Містить напівсинтетичний пеніцилін. | Приймати по 1 таблетці кожні 8 годин. Тривалість лікування 5-7 днів. Ціна – від 115 руб. |
| Еритроміцин | Чинить бактеріостатичну і бактерицидну дію. Є активним відносно грампозитивних бактерій. | Режим дозування: 1-4 г препарату на добу, розподілені на 4 прийоми. Тривалість лікування від 5 до 14 днів. Вартість – від 105 руб. |
| Цефотаксим | Препарат у вигляді порошку для приготування розчину для ін’єкцій. Протимікробну і антибактерицидной засіб. | Вводять внутрішньом’язово. В якості розчинника застосовують розчин лідокаїну або стерильну воду. 1 г речовини вводять кожні 12 год, при тяжких випадках частота введення збільшується до 3-4 разів на добу. Ціна – від 20 руб. за 1 г порошку. |
| Ципрофлоксацин | Бактерицидний препарат, активний відносно штамів стафілокока. | Засіб приймають у дозі 250-750 мг 2 рази на добу. Тривалість лікування 7-10 днів. Вартість – від 20 руб. |
При відсутності результатів лікування антибактеріальними препаратами застосовують імунотерапію з допомогою засобів пасивної імунізації: антистафілококовий плазми і імуноглобуліну. Гипериммунная антистафілококовий плазма вводиться внутрішньовенно в обсязі 4 мл на 1 кг тіла пацієнта 1 раз на добу з інтервалом 2 дні. Курс терапії складається з 4-6 сеансів.
Антистафілококовий імуноглобулін отримують з плазми, але в ній міститься в 10 разів більше бактеріальних антитіл. Для досягнення клінічного ефекту пацієнтам вводять 3-5 мл речовини через день.

Застосовуються також імуномодулюючі препарати, що прискорюють процес одужання і дозволяють не допустити розвиток супутніх патологій.
Для зміцнення імунітету використовують:
- Поліоксидоній – засіб у формі таблеток і супозиторій, що володіє комплексним імуномодулюючу та протизапальну дію. Препарат приймають по 1 табл. 2 рази на добу за півгодини до їжі протягом 10 днів. При необхідності курс лікування повторюють через 3 місяці. Ціна – від 400 руб.
- Лікопід – препарат, який виступає активатором вродженого та набутого імунітету. Зміцнює захисні функції організму. Режим дозування – по 2 табл. під язик 1 раз на добу протягом 10 днів. Вартість засоби – від 250 руб.
Антигістамінні препарати застосовуються для зняття набряклості слизової носа в період активного перебігу захворювання.
Для цієї мети використовують:
- Супрастин;

- Фенистил;
- Зодак;
- Діазолін.
Народні методи
Використання методів нетрадиційної медицини при лікуванні бактеріальної інфекції дозволяє полегшити прояви симптомів і зміцнити імунітет.
Для полегшення симптомів при захворюванні органів верхніх дихальних шляхів застосовують:
- Відвар з календули і ромашки при активному виділенні слизу з носа. По 1 ч. л. ромашки і календули залити 200 мл води і прокип’ятити протягом 5-10 хв. Приготовлений відвар остудити і процідити. Застосовувати у вигляді крапель для носа 2 рази на добу.
- Ментолове масло. Придбати масло можна в будь-якій аптеці і закопувати його по 3 краплі в кожну ніздрю. Ментолове масло застосовують для лікування затяжного нежитю або гаймориту, полегшує дихання і знімають набряклість слизової.
- Звіробій при нежиті. 2 ч. л. звіробою залити 100 мл окропу і настояти протягом 2 ч. Згорнути з вати тампони, обмокнуть їх в отриманому розчині і ввести в носові проходи на 10-15 хв. Повторювати процедуру 2 рази в день.

- Інгаляції при гаймориті або фарингіті. Найпростішим способом інгаляцій в домашніх умовах є застосування відвареної картоплі. Тільки що зняту з плити каструлю з картоплею поставити на стілець, нахилитися до неї, дотримуючись безпечну відстань і вдихати пари, що виходять від картоплі. Проводити процедуру можна за умови відсутності підвищеної температури тіла.
Для зміцнення імунітету застосовуються:
- ехінацея;
- глід;
- шипшина;
- звіробій.
З перерахованих рослин готують відвари і настої для вживання всередину.
Інші методи
Стійкість штамів стафілокока до багатьох груп антибіотиків спонукала на пошук інших методів боротьби з бактерією. До таких методів відносять застосування бактеріофагів – спеціальних агентів, що володіють всіма властивостями вірусів. Проникаючи в клітини бактерії, вони знищують їх.
Бактеріофаги – речовини вузькоспрямованої дії, тому при їх використанні важливо знати, який конкретний штам стафілокока піддають знищенню. Фаготерапія ефективна при лікуванні ЛОР-захворювань. У таких випадках бактеріофаги приймають перорально або у вигляді закапувань в носові проходи.
Для симптоматичного лікування при синуситі, риніті, фарингіті і гаймориті застосовується фізіотерапія:
- фототерапія з ультрафіолетовим випромінюванням;
- лазерна терапія;
- електрофорез;
- ультрависокочастотна терапія (УВЧ);
- інгаляції.
Небезпечний золотистий стафілокок – питання, на яке медицина давно дала позитивну відповідь і розробила цілий комплекс профілактичних заходів, дотримання яких знизить ризик зазнати даного інфекційного захворювання практично до нуля.
Найголовніше – це дотримання правил особистої гігієни і своєчасне лікування будь-яких інфекційних і простудних захворювань.
У міру можливості потрібно уникати будь-яких контактів з хворими стафілококом, а медичним працівникам рекомендована обов’язкова вакцинація і суворе дотримання правил при діагностиці і лікуванні інфікованих.
Також слід з особливою обережністю приймати антибіотичні та протимікробні засоби.
Для протистояння появі будь-яких ознак золотистого стафілокока необхідно постійне зміцнення імунної системи – вітамінотерапія, здоровий спосіб життя, заняття лікувальною фізкультурою.
Якщо хоча б один з членів сім’ї піддався зараженню, всі проживаючі з ним повинні пройти обов’язкову лабораторну діагностику на наявність бактерії.
З важливих профілактичних заходів можна виділити прийом здорової їжі і повна відмова від шкідливих звичок.
У дорослих симптоми захворювання в носі проходять вже через тиждень після початку лікування. Якщо лікування супроводжувати процедурами, спрямованими на зміцнення захисної функції організму, хвороба повністю виліковується за 10-14 днів. Рецидиви зустрічаються рідко. Працездатність відновлюється повністю.

Знайшли помилку? Виділіть її та натисніть Ctrl + Enter
Методи лікування захворювання
Для лікування стафілокока в носі лікуючий лікар призначає антибіотики нового покоління, золотистий стафілокок у патогенном стані несприйнятливий до великої кількості ліків. Найбільш успішно з ним борються препарати оксациліну, диклоксациліну, цефтріаксону.
Ними обробляються пошкоджені ділянки після розкриття гнійників. Активні речовини препаратів пригнічують стійкість мікробів. Спосіб застосування призначається індивідуально.
Якщо є можливість не використовувати антибіотики, призначають віруси, що вбивають бактерії.
Якщо стафілококова інфекція не піддається лікуванню антибіотиками, то використовують антистафилакокковый імуноглобулін, анатоксин. Вони знімають інтоксикацію.

Імуностимулюючі препарати відновлюють захисні функції організму. Застосування вітамінних комплексів зміцнює життєвий тонус. Для позбавлення від шкідливих речовин рекомендується вживати велику кількість рідини.
Тавегіл, Діазолін, інші антигістамінні препарати призначаються для зняття набряків слизової носа.
Цілителі радять застосовувати всередину невеликої кількості настою з ехінацеї, шавлії, шипшини, звіробою, ромашки.
Метод лікування народними засобами полягає в імуностимуляції організму. Головна роль у боротьбі з запаленнями відводиться антибіотиків.
Місцева обробка
У комплексі з іншими методами лікування призначають місцеву обробку Мірамістином, Хлоргексидином.
Гнійничкові ураження змащують Еритроміцинову, Тетрациклінової маззю.
Протаргол (Сиалор), Изофра, Полидекс мають судинозвужувальну властивість. Зменшує закладеність носа.
Лікування дітей
Золотистий стафілокок в носі у дитини лікується так само, як і у дорослих. Єдина відмінність – зменшення дозування препаратів, що застосовуються в зв’язку малою масою тіла дітей.
Чим лікувати стафілокок у немовлят? Важко переноситься захворювання новонародженими. Небезпечні ускладнення на серцевий м’яз, які виникають після перенесеного захворювання.
Першим ділом при виявленні стафілококової інфекції все оточення новонародженої здає мазок на бак. посів, він є визначником появи патогенних бактерій.
Курс лікування – кілька місяців. Разом з антибіотиками малюкові призначаються препарати, що підвищують імунітет, поліпшують мікрофлору кишечника.
Терапія стафілокока представлена прийомом сильних антибактеріальних засобів, як загальної, так і місцевої дії. Зважаючи великого ризику виникнення ускладнень лікування призначається спеціалістом після отримання даних про морфологію збудника. Антибіотики, що застосовуються в лікуванні бактеріальної інфекції носа і зіву:
- Биопарокс-спрей – препарат місцевої дії, проникає все слизові шари, викликаючи загибель бактеріальної мікрофлори;
- Мупироцин-мазь – застосовується з метою усунути інфекцію в носі і поверхневих шарів обличчя.
До засобів від стафілокока в носі загальної дії відносяться такі таблетовані препарати як:
- Офлоксацин;
- Амоксицилін;
- Цефтриаксон;
- Амоксиклав.
Лікування стафілокока в носі у дорослих антибіотиками здійснюється тривалий час. Курс лікування встановлюється лікарем. Переривати прийом антибіотиків неприпустимо, інакше захворювання перейде в хронічну форму, або розвинуться несприятливі ускладнення.
Крім антибіотиків призначаються місцеві імуномодулюючі краплі, противірусні препарати загальної дії, антисептичні розчини для промивання порожнин носа (на основі солі), регенеруючу мазь від стафілокока в носі і вітамінні комплекси.
Деякі фахівці рекомендують «припікати» осередки спеціальним метиленовим синім реактивом. Досить часто для усунення мікробної інфекції стафілококового генезу застосовують противостафилококковый бактеріофаг (імуноглобулін, що дозволяє зупинити ріст бактерій, і привести до руйнування клітинної стінки).
Лікувати стафілокок необхідно тільки тоді, коли починає розвиватися запальний процес. Присутній в організмі людини з сильним імунітетом у малих кількостях, цей мікроорганізм не завдасть йому шкоди.
Він просто буде жити на слизовій. Проте з ним потрібно бути напоготові. Все ж це умовно-патогенна бактерія. А це означає, що вона безпечна для людини до пори до часу. Навіть мінімальний збій імунітету може дати зелене світло активного розмноження стафілокока.
Сьогодні в процесі лікування, який оселився в носі стафілокока медики стикаються з серйозною проблемою. Вона полягає в резистентності (стійкості) цього мікроорганізму до більшості існуючих препаратів.
З того часу, коли світ дізнався про пенициллине, стафілокок встиг значно мутувати. Тому цілком логічно, що багато його різновиди стійкі до антибіотиків цієї групи. Довелося вносити в пеніцилін зміни.
Отже, перш чим призначати той чи інший антибіотик, доктор робить спеціальний аналіз і з’ясовує, наскільки чутливий до нього шкідливий мікроорганізм. Це потрібно для того, щоб успішно вилікувати стафілококову інфекцію.
Якщо стафілококова інфекція здобула важку форму, до пацієнту потрібен комплексний підхід. Йому в індивідуальному порядку виписують найбільш ефективні антибіотики, які ліквідують патогенні мікроорганізми.
Крім того, будуть призначені імуномодулюючі ліки та краплі назальні. Пам’ятайте, що лікувати таку інфекцію необхідно тільки під контролем медиків. Адже ефективність лікування напряму залежить від грамотного підбору препаратів.
Якщо вступити в боротьбу з хворобою самостійно, це може бути як мінімум марно і як максимум – небезпечно для здоров’я. Ви упустите час, а шкідливі бактерії як раз скористаються ним для ще більш активного розвитку.
Стафілококову інфекцію лікують антибіотиками і обробкою носових ходів антисептичними препаратами. Якщо захворювання протікає безсимптомно, антибактеріальне лікування не призначається. Пацієнту рекомендується приділити більше уваги заходам щодо зміцнення імунітету.
Якщо запальні процеси в носі носять хронічний або рецидивуючий характер, а бактеріологічний аналіз показав присутність великої кількості стафілококових клітин у виділеннях носоглотки, лікар призначає антистафілококову терапію. Її основні принципи:
- Лікування може проводити тільки лікар – лор, терапевт або педіатр.
- Перед призначенням ліків проводять визначення резистентності бактерій до груп антибіотиків.
- Самолікування не допускається, так як стафілококова інфекція важко піддається звичайному лікуванню. Для позбавлення від неї доводиться використовувати комплексну терапію.
Від стафілококової інфекції можна позбутися за допомогою Амоксиклаву та антибіотиків групи трициклічних глікопептидів, пеніцилінів, цефалоспоринів.
ммЛечение доповнюють натуральними антисептиками. Широко застосовується препарат Хлорофіліпт, масляний розчин якої використовують для лікування інфекцій навіть у маленьких дітей.
Хлорофіліпт закапують у ніс по дві-три краплі в кожну ніздрю тричі на день або ставлять турунди, просочені препаратом. Призначають мазь Мупироцин – бактерицидний засіб широкого спектра дії, що згубно діє на стафілококи, в тому числі золотистий і метиленрезистентные штами.
Штами, стійкі до антибіотиків, знищують особливими препаратами, що містять лізати бактерій, тобто частинки стафілококів та інших мікроорганізмів. Дані препарати підсилюють вироблення в крові антитіл і підвищують природний захист організму. Лізати до стафілокока містяться в препаратах: ІРС 19, Імудон, Бронхомунал.
Люди зовсім недавно дізналися про золотистому стафилококке, але народні цілителі уміли справлятися з інфекціями ще до винаходу антибіотиків. У деяких природних засобах містяться потужні антибактеріальні сполуки.
Наприклад, для метиленустойчивого Staphylococcus aureus, практичні невразливим для будь-якого сучасного ліки, вкрай згубні фітонциди, що містяться в цибулі, часнику, ягодах. Науково доведено, що Staphylococcus aureus та туберкульозні палички гинуть від фітонцидів капусти і хрону.
У багатьох диких травах міститься потужний спектр природних сполук, здатних впоратися зі стафілококами. До їх числа відносяться шавлія, звіробій, чистотіл. Дослідження показали, що природні антибіотики растенияй, не поступаються по ефективності синтетичним.
Сильну антибактеріальну дію має ефірне масло. Одне з найбільш ефективних у боротьбі зі стафілококами засобів – ефір чайного дерева. Олії застосовують у вигляді сухих і вологих інгаляцій, полоскань.
Терапія повинна призначатися виключно лікарем. Самолікування може призвести до того, що стафілокок виробить власний імунітет до препаратів, що ускладнить процес подальшої боротьби з ним.

Медикаментозне лікування включає в себе наступні групи препаратів:
- підібрані в лабораторії антибіотики, серед препаратів вибору:
- Цефалексин;
- Ципрофлоксацин;
- Амоксиклав;
- Ко-тримоксазол;
- засоби для імуномодуляції:
- Іммунал;
- Бронхомунал;
- Деринат;
- вітаміни і мінерали:
- засоби проти алергії, які сприяють зняттю набряку:
Крім цього, лікар призначає лікування недуг, які розвинулися внаслідок стафілококової атаки.
Для посилення ефекту призначеного лікування радять використовувати такі засоби:
- розчини антисептиків для промивання порожнини носа:
- Фурациліну;
- Діоксидин;
- Мірамістину;
- Хлоргексидину;
- судинозвужувальні краплі або спреї для порожнини носа, що володіють антибактеріальним ефектом:
- антибактеріальні мазі при появі в носі гнійників:
- Тетрациклінову;
- Еритроміцинову;
- Банеоцин;
- Фузидин;
- перекис водню 3%, яку розбавляють водою в пропорції 1:10, для промивання носа;
- краплі на олійній основі:
Можливі ускладнення
Стафілокок в носі у дорослих, що провокує ряд симптомів, що може викликати ускладнення в разі, якщо не розпочато своєчасне і комплексне лікування.
До наслідків бактеріальної інфекції належать:
- важка форма пневмонії;
- проникнення в кровоносну систему, яке потягне за собою розвиток сепсису;
- формування рубців на слизовій оболонці носа;
- приєднання іншої бактеріальної інфекції;
- ураження інших органів у разі поширення бактерії з організму.
Стафілокок в носі у дорослих не завжди супроводжується проявом симптомів і тривалий час знаходиться на слизовій порожнини без розвитку патології. Часті нежиті, ускладнені запальними процесами, свідчать про активізацію бактеріальної інфекції, яка вимагає негайного лікування.

Оформлення статті: Міла Фрідан
Всі заходи з лікування стафілококової інфекції необхідно брати в ранні терміни. Інакше розвиток захворювання може призвести до серйозних ускладнень, наприклад:
- розвитку менінгіт — запалення оболонок мозку;
- виникнення СТШ (синдрому токсичного шоку) — важкого захворювання, яке вражає практично всі органи одночасно;
- розвитку сепсису — поширенню інфекції по всьому організму з током крові;
- эндокардиту — запалення внутрішньої оболонки серця.
Стафілокок в носі може призвести до серйозних порушень здоров’я, а у важких випадках стати причиною загибелі пацієнта. Бактерії проникають в нижні дихальні шляхи, через руки переносяться по всьому тілу, а пі попаданні в дрібні рани потрапляють у системний кровотік. Такий стан (при відсутності лікування) закінчується септичним шоком та загибеллю хворого.
При неповному лікуванні, інфекція переходить у хронічну форму, вражаючи імунну системи, і нагадуючи про себе з періодичністю 2-3 рази на рік.
Виявлені мікроби в порожнині носа і зіву погіршують перебіг захворювання, викликають різні ускладнення і ускладнюють лікування недуги.
Що не можна робити хворому?
Існує ряд протипоказань:
- заборонено вдаватися до согревательным процедур;
- не можна прогрівати носоглотку, використовувати компреси;
- необхідно виключити з харчування мед, молочні продукти, соки;
- не можна санувати порожнину носа спиртовмісними речовинами;
- заборонено самостійно розкривати гнійники біля носа.
Золотистий стафілокок, стійкий до спирту, спиртові розчини сушать слизову.
Профілактичні заходи
Зрозуміло, будь-яку хворобу набагато легше попередити, чим лікувати. Це ж правило діє і у випадку зі стафілококом.
Найбільш результативна міра профілактики – регулярно займатися зміцненням власного здоров’я та імунітету. Крім того, обов’язково потрібно дотримуватися адекватного режиму відпочинку і сну, бажано займатися яким-небудь видом спорту, проводити достатньо часу на свіжому повітрі, дотримуватись правил здорового харчування і вчасно пролечивать хвороби інфекційного походження. Слід зазначити, що також дуже важливо стежити за особистою гігієною і чистотою в оселі.
Найчастіше стафілококова інфекція вражає найбільш слабких. Їй більше за інших схильні вагітні, малюки до року, літні люди і ті, хто часто застуджується. Їм необхідна посилена профілактика:
- як тільки з’явився найменший натяк на нежить, тут же промити ніс (рекомендується користуватися розчином кухонної солі);
- як можна частіше мити підлогу і витирати пил в кімнатах;
- провітрювання кімнат повинно стати щоденною традицією;
- хвороби ротової порожнини і верхніх дихальних шляхів треба лікувати відразу ж після появи перших симптомів;
- перед тим як приступити до годування дитини, в обов’язковому порядку вимити і руки, і груди;
- не забувати проходити щорічний (кому потрібно – частіше) огляд у свого лікаря і у інших фахівців.
https://www.youtube.com/watch?v=UyMiemJS8ZU
Медиками виведений список профілактичних заходів для хворих під час лікування золотистого стафілокока в носі:
- Дотримання правил особистої гігієни.
- Профілактичне промивання носа сольовими розчинами, мінеральною водою без газу.
- Регулярне застосування комплексу вітамінів з мінералами.
- Раціональне харчування.
- Загартовування.
- Уникнення переохолодження організму.
- Постійне зволоження повітря у приміщенні.
- Регулярне провітрювання приміщення.
Дотримання перерахованих вище заходів профілактики запобігає розвитку інфекції в носі, а також передачу іншим людям патогенних бактерій золотистого стафілокока.


